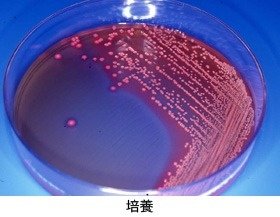

動物たちの検査II<細菌検査>
動物病院だより
動物たちの健康を損なう原因の一つに細菌感染があります。検査でこの細菌検査を監視し、コントロールすることは、動物病院の重要な仕事の一つです。 細菌はわずか1〜数マイクロメーター(1マイクロメーターは1mmの1/1000)前後ととても小さいので、そのままでは探し出すことはもちろん種類を知ることなどとてもできません。したがって細菌を検査するためには、まずその細菌を増殖させること(培養)から始まります。一般に、細菌の成育に必要な栄養分の入った寒天培地に材料を接種し、孵卵器(37度)に入れて培養します。細菌の種類によっては、特殊な培地でしか育たないもの、酸素のない環境でしか育たないもの、低温の方が増殖しやすいものなどと様々で、それぞれに合った条件で培養する必要があります。やがて細菌は数mmの丸い「コロニー」という塊を作ります。実はこのコロニー1つは1個の細菌が増殖してできたものなのです。このコロニーの色、形で大まかな種類を推定します。そして、顕微鏡で細菌の形態を観察したり、生化学的な特徴などを調べ、細菌の種類を特定するのです。これを同定と言います。普通、培養から菌種同定まで数日を要しますが、中には培養に数ヶ月もかかる細菌がいて、結構長い付き合いになるのです。
前回紹介した寄生虫検査と同じく、検査対象として多いのが糞便です。新着動物の検疫や下痢をした時などに検査し、有害細菌が侵入するのを水際で防ぎます。しかし、ここで動物の種類や食性の違いにより、普段保有している細菌(常在菌)の種類が異なることがあります。たとえば、プレシオモナス・シゲロイデスという細菌は、ヒトで下痢症を起こすことがありますが、海鮮魚を食べるアシカやペンギンでは健康な個体からもごく普通に検出されます。このように各動物ごとにその特性を把握しておかないと、正確な診断ができません。皮膚、耳、目、気管支、膀胱などの炎症には細菌が関与する可能性があり、それぞれ患部からサンプルを取り検査を行います。また、動物が死亡した時にはその原因を調べるために解剖を行いますが、その際にも細菌検査は重要な決め手になります。
いずれにしても、病原菌を検出した場合には、直ちにどんな抗生物質が有効かテスト(薬剤感受性テスト)を行い、適切な薬剤を投与することになるのです。その他、細菌検査の特殊な目的として、動物に与える餌の中に病原菌が潜んでいないか検査したり、動物の泳ぐプールの水に含まれる大腸菌数を調べ水の汚れの指標とします。
このように細菌検査は、様々な形で動物園動物の健康管理に貢献しているのです。